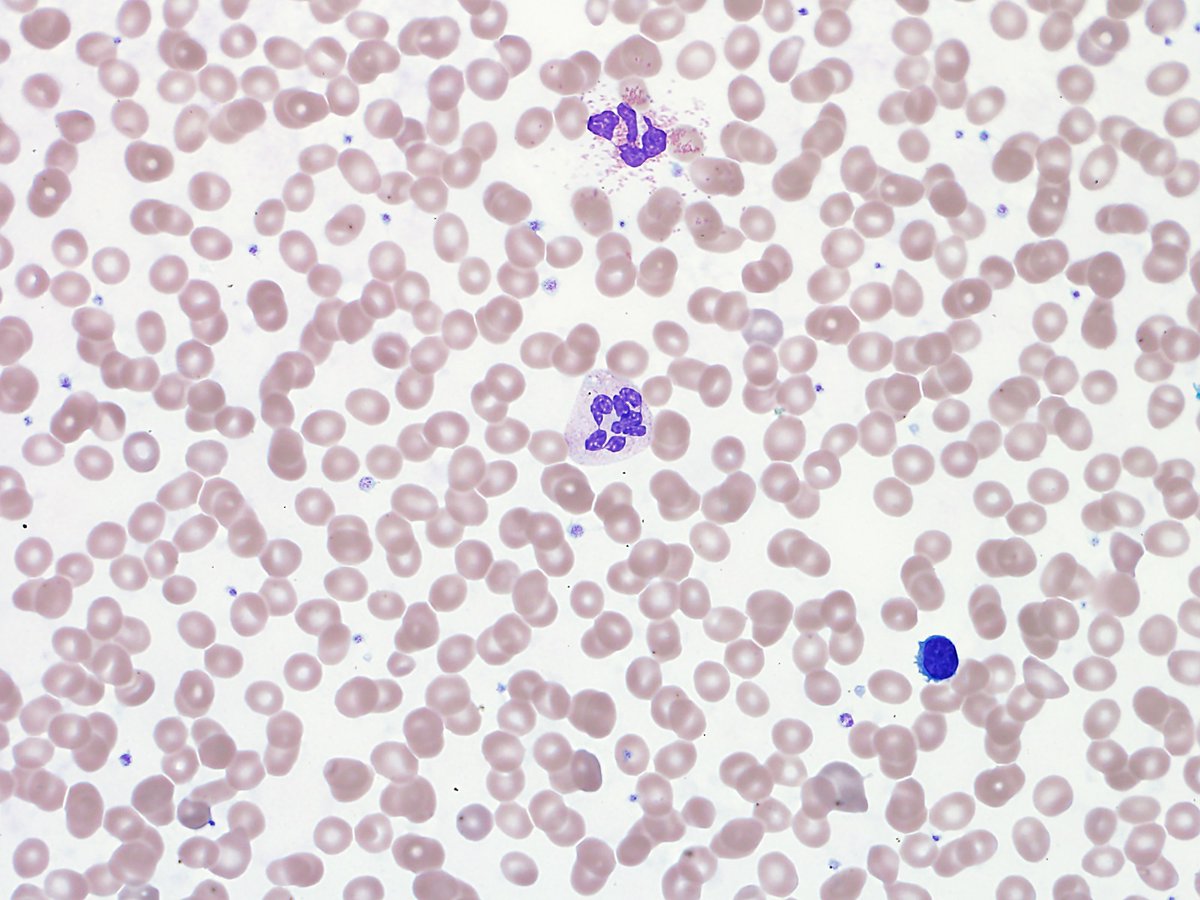
Mrinal Patnaik tweet media

@DavidSteensma @ASH_hematology Hi, love the ASH crossword puzzle every year. Have you posted the 2024 answers yet?
English
Mark Litzow
27 posts

@MRLitzow
I am a hematologist, professor of medicine and specialist in blood and marrow transplantation and in the treatment of acute and chronic leukemia

















"Rather than constraining patients into either #transfusion or hospice models, policies that promote combining palliative transfusions with hospice services are likely to optimise end-of-life care" NEW viewpoint by Oreofe Odejide & @DavidSteensma #hemonc thelancet.com/journals/lanha…

@MRLitzow @ASH_hematology Wasn't it R-Ibrutinib > FCR?
